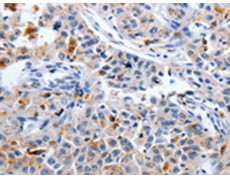
一抗

中文名稱:兔抗CDK3多克隆抗體
英文名稱: Anti-CDK3 rabbit polyclonal antibody
相關(guān)類別: 一抗
儲 存: 冷凍(-20℃)
抗 原: CDK3
宿 主: Rabbit
反應(yīng)種屬: Human, Mouse
標(biāo) 記 物: Unconjugate
克隆類型: rabbit polyclonal
技術(shù)規(guī)格
|
Background: |
This gene encodes a member of the cyclin-dependent protein kinase family. The protein promotes entry into S phase, in part by activating members of the E2F family of transcription factors. The protein also associates with cyclin C and phosphorylates the retinoblastoma 1 protein to promote exit from G0. Serine/threonine-protein kinase that plays a critical role in the control of the eukaryotic cell cycle; involved in G0-G1 and G1-S cell cycle transitions. Interacts with CCNC/cyclin-C during interphase. Phosphorylates histone H1, ATF1, RB1 and CABLES1. ATF1 phosphorylation triggers ATF1 transactivation and transcriptional activities, and promotes cell proliferation and transformation. CDK3/cyclin-C mediated RB1 phosphorylation is required for G0-G1 transition. Promotes G1-S transition probably by contributing to the activation of E2F1, E2F2 and E2F3 in a RB1-independent manner. |
|
Applications: |
ELISA, IHC |
|
Name of antibody: |
CDK3 |
|
Immunogen: |
Synthetic peptide of human CDK3 |
|
Full name: |
cyclin-dependent kinase 3 |
|
SwissProt: |
Q00526 |
|
ELISA Recommended dilution: |
1000-5000 |
|
IHC positive control: |
Human lung cancer |
|
IHC Recommend dilution: |
25-100 |

 購物車
購物車 幫助
幫助
 021-54845833/15800441009
021-54845833/15800441009